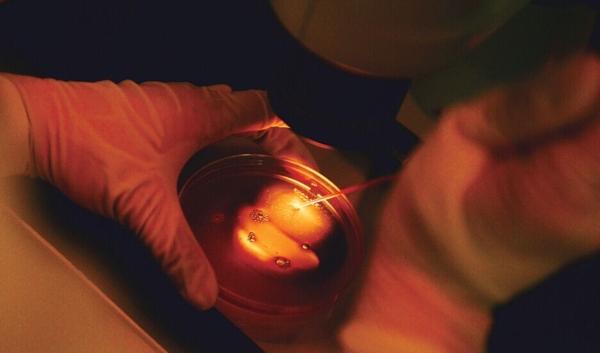

囊胚解冻后几小时移植?具体要看女性身体情况
- 试管婴儿
- 2023-04-04 09:20
囊胚解冻后等多久才能再移植是大家比较关心的一个问题,其实这个移植的时间并非越早越好,一般在解冻前医生都会看女性的身体情况,从解冻到移植也不会等很长的时间,具体如下:
囊胚解冻后几小时移植
试管囊胚解冻后几小时移植?
首先大家要知道的是囊胚解冻的时间一般在半小时,往往在解冻后需要尽快的移植到子宫内,从复苏到移植的这个时间越早越好,因为在外停留越久越不利于胚胎的发育。
镜头下一颗颗处于卵泡液中的卵子
而在确定囊胚解冻复苏的时间前,往往会对女性身体做一个基础的检查,主要会看看子宫内膜是否处于受孕的最佳状态,即种植窗,只有当子宫内膜达到种植窗时进行胚胎移植,胚胎才可顺利着床。
所以说依照冷冻时的胚胎不同其解冻后再移植的时间也会不一样,比如冷冻时是第三天的胚胎,需按照排卵后第三天的日期进行解冻和移植,若冷冻的是第五天的胚胎,需推迟两天解冻,才可达到胚胎与内膜发育的同步性,提高妊娠率。
冷冻胚胎解冻复苏后通知单
此外囊胚解冻前也会观察女性激素水平是否达到要求、身体有无其它疾病等,只有所有条件均符合,才可进行胚胎的解冻和移植,否则会降低妊娠率,浪费宝贵的胚胎。
总之解冻囊胚具体多久移植要看女性的身体情况,从网上查询到的一些回答,有的上午解冻下午移植,也有的早上八点多报的解冻胚胎数十一点多移植的,也就是说一般解冻后当天就会进行胚胎移植手术。
胚胎解冻后移植的时间,则可随时解冻胚胎进行移植
其实在囊胚解冻前都会让女性做一个检查,只有检查合格才会告诉你准备解冻,不过解冻当天也是要检查的,再次确认各项指标是否都合格,只有身体条件达到胚胎移植的标准才能进行移植。
一般情况下解冻后的胚胎会在体外培养复苏2-4个小时后即可进行移植手术,所以囊胚解冻移植的流程比较短,大家具体要看生殖中心医生的安排。

发表评论